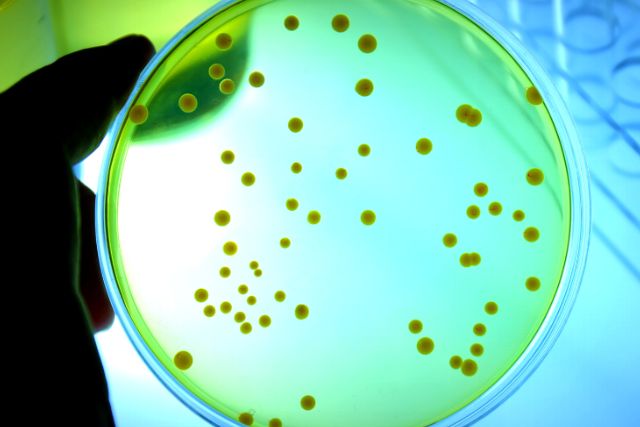
Blog Image

Getting there faster: New developments in rapid microbiology
Early and accurate pathogen identification is essential to optimise patient care. This includes assigning he correct antimicrobial to treat a specific pathogen of concern. This is an area where rapid methods can prove highly beneficial. The conventional approach for pathogen identification involves adding blood samples to bottles of liquid media in which infectious microbes, if present, are amplified to a certain density.
Introduction
Improving the time-to-result and doing so with greater accuracy has become a topic of concern for the microbiology laboratory as much as it has for other economic sectors. Achieving the result early may improve the chances of patient survival or it may help a firm to reduce inventory hold times.
There is a wide spectrum of rapid microbiological methods available, albeit some are at a more advanced stage than others. Technologies vary although the generally share the ability to capture data digitally and they offer greater accuracy and specificity. Such methods are also shifting the traditional skill sets found in microbiology laboratories towards biochemistry and biomedical engineering.
Focusing on innovations within the rapid microbiology space that have occurred during the past 12-18 months (2021 to 2022), this article surveys and explains some of the most promising rapid microbiological innovations.
Rapid method for pathogen detection in blood
Early and accurate pathogen identification is essential to optimise patient care. This includes assigning he correct antimicrobial to treat a specific pathogen of concern. This is an area where rapid methods can prove highly beneficial. The conventional approach for pathogen identification involves adding blood samples to bottles of liquid media in which infectious microbes, if present, are amplified to a certain density.
These organisms are then grown on solid media and isolated colonies are identified using microbial identification systems like MALDI-TOF mass spectrometry (MS) (1). Read More…







